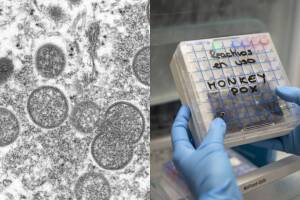
viruela del mono.jpg

Brote
Brote: Últimas noticias, videos y fotos de Brote
- article2 Min ReadOctober 24, 2024 09:35 PMAl menos 49 personas en 10 estados han sufrido intoxicación alimentaria por E. coli tras comer en restaurantes de la cadena McDonlads, 10 de ellos terminaron hospitalizados. Ahora la empresa asegura que el brote se originó en California. Esto es lo que se sabe.
- article2 Min ReadOctober 24, 2024 03:20 PMMcDonald’s y agencias federales buscan determinar con precisión cuál fue el ingrediente contaminado con la bacteria E. coli.
- article2 Min ReadOctober 11, 2024 12:52 PMLa empresa con sede en Oregón dijo que ordenó sacar del mercado los productos luego de que inspectores detectaron listeria en muestras de los productos alimenticios en una de sus plantas.
- article3 Min ReadFebruary 22, 2024 10:41 PMSeis casos se han reportado en una escuela primaria del condado Broward, lo que ha encendido las alarmas entre la sociedad y las autoridades.
- article6 Min ReadJanuary 23, 2024 07:14 PMAunque el sarampión se declaró eliminado en EEUU en 2000, la inmunización contra el virus sigue siendo fundamental para que se presenten nuevos casos.
- article2 Min ReadSeptember 21, 2023 07:32 PMQuinta demanda por parte de una de las 55 víctimas que contrajeron una infección transmitida por alimentos en una taquería de las Carnicerías Guanajuato.
- article1 Min ReadMay 20, 2023 12:43 PMLa bacteria ha infectado a 81 personas, incluidas cuatro que murieron y 14 que perdieron la vista, informaron el viernes los Centros para el Control y la Prevención de Enfermedades.
- article2 Min ReadNovember 09, 2022 11:30 PMLa mayoría de los infectados terminan hospitalizados. Se reporta que una mujer embarazada perdió a su bebé y una persona perdió la vida.
- article1 Min ReadSeptember 16, 2022 10:08 AMAutoridades sanitarias sospechan de al menos ochocaso de personas infectadas por esta bactería. Cuatro residentes han muerto, de los cuales dos ya dieron positivo a la Legionella.
- article1 Min ReadAugust 06, 2022 05:17 PMUn estudio realizado por la Universidad de Stanford encontró rastros de ADN del virus en el alcantarillado de la ciudad.